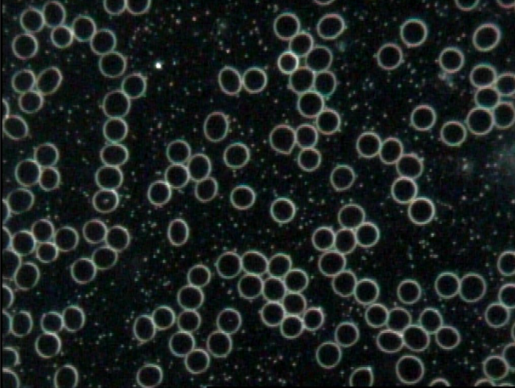

Unveiling the Untold: What Live Blood Analysis Reveals Beyond Routine Blood Panels
When it comes to understanding our health, blood tests play a crucial role in providing valuable insights into our internal well-being. Routine blood panels have long been the go-to diagnostic tool for assessing various aspects of our health. However, in recent years, a lesser-known technique called live blood analysis (LBA) has gained attention for its potential to capture additional health information that routine blood panels may not reveal.
Understanding Live Blood Analysis:
Live blood analysis, also known as dark-field microscopy, is a diagnostic technique that involves the examination of fresh, unaltered blood samples under a specialized microscope. Unlike routine blood tests that are sent to a laboratory for analysis, LBA is performed on-site, allowing for immediate observation of the blood's live state.
For me, this analysis helps me see the subtle warning signs of a problem, before it becomes a real problem. I like to see where my health is trending. This allows me to make minor tweaks to address symptoms like fatigue, brain fog, frequent colds/flu that can not be addressed by my primary care physician.
In fact, the range of results that are “within normal limits” on a routine blood test are often very wide and so “normal” may not be what is optimal. You may be creeping towards insulin resistance and diabetes but this result may not show up on your bloodwork until you blood glucose levels already out of control.
Blood sample using Dark Field Microscopy showing Red Blood Cells
What Can Live Blood Analysis Detect?
Cellular Health Assessment: Live blood analysis provides a dynamic assessment of the health and vitality of individual blood cells. By observing the blood live, practitioners can evaluate the shape, size, movement, and behaviour of red blood cells, white blood cells, platelets, and other cellular components. This level of detail can offer valuable insights into cell membrane integrity, oxidative stress, nutritional deficiencies, and overall cellular health.
Terrain Analysis: LBA goes beyond analyzing individual blood cells. It also takes into account the surrounding fluid, often referred to as the "terrain" or the extracellular matrix. By examining the terrain, practitioners can assess the presence of toxins, heavy metals, parasites, and other microscopic particles that may affect overall health. This information can provide clues about the body's detoxification capacity and potential imbalances that routine blood panels may not uncover.
Nutritional Status: Live blood analysis can provide an indication of nutritional deficiencies and imbalances. By observing the blood, practitioners may identify signs of nutrient deficiencies such as low iron, vitamin B12, or folate levels, which can impact energy levels, mood, and overall health. Moreover, LBA can help assess the efficiency of nutrient absorption and utilization by observing the state of blood cells.
Immune System Evaluation: The immune system plays a pivotal role in maintaining our health and defending against diseases. LBA can offer insights into the immune system's activity by observing the behavior and morphology of white blood cells. This can provide valuable information about the body's immune response, potential allergies, chronic infections, and autoimmune conditions.
Early Detection of Imbalances: One of the most significant advantages of live blood analysis is its potential to detect imbalances and abnormalities at an early stage. By examining blood samples in real-time, practitioners may observe subtle changes that could indicate developing health issues. Early detection can empower individuals to take proactive measures and make lifestyle changes before symptoms manifest or progress into more serious conditions.
I usually have an analysis done twice a year, once just before cold & flu season and again 6 months later to keep me at my optimum health with the change of seasons. I also reach out for acute needs when they arise like sinus infections, and anything I notice that seems off.
If you are interested in exploring this technique, schedule an appointment with Crina Cretu, Live Blood Analyst & Certified Nutritional Practitioner to tap into the potential benefits for your individual health journey.